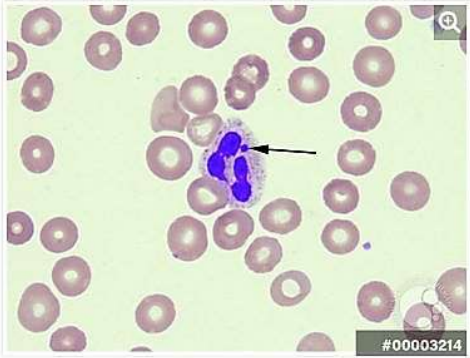
Enunciado 3029360-1

Um homem de 32 anos com diagnóstico de Leucemia Linfóide Aguda B comum de alto risco finalizou tratamento de indução com protocolo Hyper-CVAD sendo realizado outro tratamento na sequência. A figura 1 exibe o esfregaço de sangue periférico deste paciente após esta terapia. Assinale a alternativa que apresenta qual o tratamento realizado se relaciona com esse achado de esfregaço.
Figura 1. Fonte: Jon Fukumoto 07/01/2016 – arquivo imagens ASH. https://imagebank.hematology.org/
Provas
Questão presente nas seguintes provas